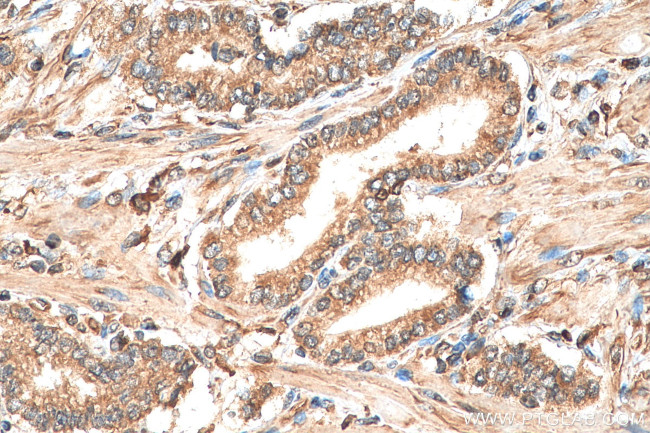
MAP3K7 Antibody in Immunohistochemistry (Paraffin) (IHC (P))

Search
Proteintech
MAP3K7 Polyclonal Antibody
{{$productOrderCtrl.translations['antibody.pdp.commerceCard.promotion.promotions']}}
{{$productOrderCtrl.translations['antibody.pdp.commerceCard.promotion.viewpromo']}}
{{$productOrderCtrl.translations['antibody.pdp.commerceCard.promotion.promocode']}}: {{promo.promoCode}} {{promo.promoTitle}} {{promo.promoDescription}}. {{$productOrderCtrl.translations['antibody.pdp.commerceCard.promotion.learnmore']}}
产品信息
29167-1-AP
种属反应
宿主/亚型
分类
类型
抗原
偶联物
形式
浓度
规格
纯化类型
保存液
内含物
保存条件
运输条件
产品详细信息
Aliquoting is unnecessary for -20°C storage.
靶标信息
TAK1 (also known as MAP3K7), a part of the serine/threonine kinase family, is a versatile protein with many signaling functions. Originally identified as a TGF- beta-activated kinase, TAK1 interacts with TGF- beta-receptor and TRAF6 to modulate TGF- beta activation of JNK and p38. It has additional roles in activation of p38 and JNK through Wnt, BMP, and activin signaling pathways as well in response to thyroid hormone, osmotic stress, endothelin, and ephrine. Through activation of von Hippel-Lindau tumor suppressor expression, TAK1 represses PDGF-B, integrin beta1 and integrin beta5, promoting proper wound healing. TAK1 also plays an essential role in IKK activation in numerous signaling pathways including IL-1, IL-6, IL-18, TNF, CD40, TLR, and RIG-I. Activation of the TAK1-IKK pathway requires TAB2/3 and ubiquitination. In this process, TAB2/3 binds to the C-terminal region of TAK1 and becomes polyubiquitinated, TAK1 is autophosphorylated at Thr178, Thr184, Thr187 and Ser192, and finally TAK1 phosphorylates IKK- beta. Additionally, TAK1 represses human telomerase reverse transcriptase suggesting a role in regulation of cell lifespan.
仅用于科研。不用于诊断过程。未经明确授权不得转售。
篇参考文献 (0)
生物信息学
蛋白别名: M3K7; Mitogen-activated protein kinase kinase kinase 7; RP1-154G14.1; TAK1d; TGF-beta activated kinase 1; TGF-beta-activated kinase 1; Transforming growth factor-beta-activated kinase 1; unnamed protein product
基因别名: CSCF; FMD2; MAP3K7; MEKK7; TAK1; TGF1a
UniProt ID: (Human) O43318
Entrez Gene ID: (Human) 6885